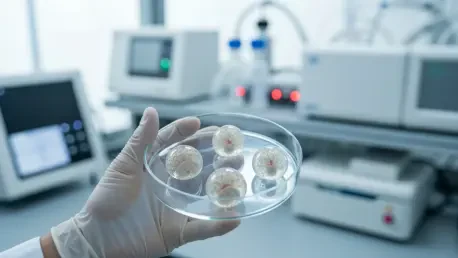
New Study Tackles Brain Damage From Life-Saving Drugs

A profound paradox exists within modern pharmacology where the treatments designed to combat deadly diseases can simultaneously inflict severe and lasting damage on the human brain. For countless individuals undergoing treatment for conditions like HIV and cancer, this is a harsh reality; up to half of all patients receiving certain FDA-approved medications experience debilitating neurological side effects, including cognitive decline and irreversible nerve damage. This clinical challenge has prompted a significant new research initiative aimed at shifting the scientific paradigm from merely documenting this damage to fundamentally understanding the precise molecular chain of events that allows these vital drugs to become toxic. Spearheaded by Professor Kamal Seneviratne, this work seeks to deconstruct the biochemistry of neurotoxicity, lighting a path toward therapies that can heal without causing harm.
The Scientific Foundation
A Landmark Discovery
The groundwork for the current ambitious project was meticulously laid by a breakthrough study published in 2024 from Seneviratne’s laboratory. This research was the first to specifically demonstrate that the widely prescribed HIV medication efavirenz causes profound disruptions to lipid metabolism within the brain. Lipids, which include fats and other essential molecules, are the fundamental building blocks of brain cells, critical for their structural integrity, communication, and overall survival. The study revealed that efavirenz throws the brain’s finely tuned lipid chemistry into a state of imbalance. More importantly, the investigation showed that these disruptions were not a generalized effect but were instead concentrated in specific, localized regions of the brain. This finding provided an essential clue, suggesting that certain neural populations are more vulnerable than others. The work, led by Ph.D. candidate Nav Phulara, established a direct and measurable link between the drug and a specific type of molecular damage, providing the critical foundation upon which a much larger investigation could be built.
Expanding the Investigation
Building on the momentum of this initial success, the Maryland Stem Cell Research Fund (MSCRF) has awarded Seneviratne’s team a substantial $350,000 grant, enabling a significant expansion in both the scope and depth of their research. This new funding empowers the scientists to broaden their focus beyond efavirenz to include two other widely used drugs known for their neurotoxic potential: dolutegravir, another prominent HIV medication, and oxaliplatin, a common chemotherapy agent. The core objective of this expanded project represents a crucial evolution in the scientific approach. The team is moving beyond simply identifying what damage is occurring to meticulously mapping out how it happens at the most fundamental molecular level. By dissecting the specific biochemical pathways that these drugs disrupt, the researchers aim to create a detailed blueprint of drug-induced neurotoxicity. This deeper understanding is the essential next step toward developing effective strategies to prevent or mitigate these devastating side effects for patients who depend on these life-saving treatments.
A New Approach to Understanding Neurotoxicity
Cutting-Edge Tools and Models
Central to this new phase of research is the strategic use of innovative methodologies designed to circumvent the well-documented limitations of past neurotoxicity studies. Through a key collaboration with neurologist Dr. Jinchong Xu at Johns Hopkins University, Seneviratne’s team will employ human “brain organoids.” These are not simple cell cultures but sophisticated, three-dimensional clusters of human brain cells grown in the laboratory from stem cells. This model represents a paradigm shift, moving away from traditional animal studies which, as Seneviratne notes, often fail to accurately predict human responses due to significant species differences. The organoids much more closely mimic the complex cellular environment, architecture, and physiological functions of a developing human brain. This provides an unprecedented and ethically sound window to observe precisely how these therapeutic drugs interact with and inflict damage upon human neural tissue directly, offering a level of accuracy and relevance that was previously unattainable.
To analyze these complex models, the laboratory will deploy a powerful and holistic suite of advanced analytical techniques to capture a comprehensive molecular snapshot of the drug’s impact. The first is MALDI Mass Spectrometry Imaging (MSI), a high-resolution technique that allows researchers to visualize the precise spatial distribution of thousands of molecules directly within an intact tissue sample. Unlike conventional methods that require grinding up the tissue—thereby losing all crucial information about where molecules are located—MALDI MSI can pinpoint the exact location of the drugs, their breakdown products (metabolites), and the various lipids they affect within the intricate structure of the brain organoids. Complementing this imaging technology is proteomics, the large-scale study of the entire set of proteins within a tissue. This allows the team to measure how the drugs alter the expression and function of key proteins involved in cellular health, metabolism, and survival, providing critical insights into the upstream effects on molecular pathways that lead to cellular dysfunction.
Future Impact on Patient Care
The primary ambition of this MSCRF-funded project was to translate its fundamental scientific discoveries into tangible and impactful benefits for clinical practice. By identifying the precise molecular warning signs and biochemical pathways that culminated in neurotoxicity, the research aimed to uncover early and reliable biomarkers. The discovery of such biomarkers would have equipped clinicians with the tools necessary to monitor patients undergoing treatment, allowing for timely intervention well before any neurological damage became permanent. This proactive approach represented a significant shift from reactive treatment of symptoms to preventative care, promising to safeguard the long-term neurological health of patients who relied on these essential but potentially harmful medications. It was a vision of personalized medicine where treatments could be tailored or supplemented to protect the brain, ensuring that the cure was not as devastating as the disease itself.
Furthermore, the project’s findings were intended to have a lasting impact on the pharmaceutical industry by informing the development of safer, next-generation drugs. By pinpointing the specific molecular liabilities that made certain compounds toxic, this research provided a new framework for drug design and a set of powerful screening tools to evaluate drug candidates early in the development pipeline. This knowledge was expected to help pharmaceutical companies engineer new medicines that retained their therapeutic efficacy while minimizing or eliminating their harmful effects on the brain. The MSCRF grant actively encouraged this translation from lab to market, and the project’s insights held the potential to spin off into new commercial tools or even a startup company dedicated to neurotoxicity screening. Ultimately, the work was designed to bridge the critical gap between basic science and patient outcomes, providing a new arsenal of strategies to protect the brain while treating deadly diseases.